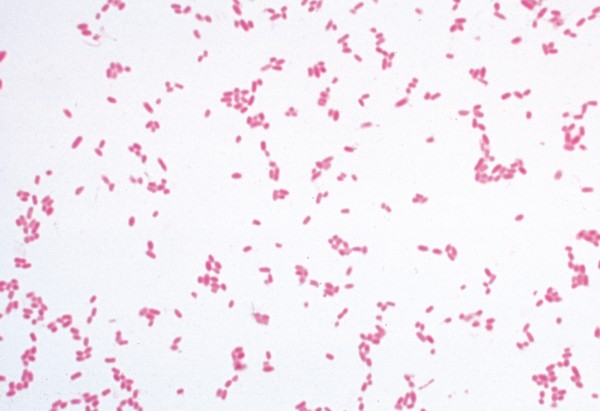

- Best.-Nr.: 400327
- Info zur LIeferzeit: Herstellerlieferung
Jedes einzelne Präparat ist sorgfältig ausgewählt und auf seinen Lehrwert hin überprüft worden.
- LIEDER Mikropräparate werden in unseren Laboratorien unter wissenschaftlicher Leitung hergestellt.
Sie sind das Ergebnis jahrzehntelanger Erfahrung auf allen Gebieten der Präparationstechnik.
Die Herstellung der Mikrotomschnitte erfolgt durch erfahrene Fachkräfte, Schneidetechnik und Schnittdicke werden den Objekten angepaßt.
Aus der großen Zahl der in der Mikroskopie üblichen Färbemethoden wählen wir solche, die eine klare und kontrastreiche Darstellung der gewünschten Strukturen mit bester Haltbarkeit verbinden.
Meist handelt es sich dabei um aufwendige Mehrfachfärbungen.
- LIEDER Mikropräparate werden auf feinbekanteten Objektträgern im Format 26 x 76 mm geliefert.
Die Anzahl der vorhandenen Präparateserien, oder zumindest von Teilen daraus, sollte in etwa der Zahl der vorhandenen Mikroskope entsprechen, so daß mehrere Schüler gleichzeitig die gleichen Präparate untersuchen können.
ACHTUNG:
der Preis versteht sich inkl. einer Transportmappe für 1 Präparat im Wert von 2,90 Euro
Mikroskopische Präparate können aus technischen Gründen nur in speziellen Mappen bzw. Kästen versandt werden !
Bei einer größeren Abnahme von Präparaten kontaktieren Sie uns bitte.
| Gebiet: | Krankheitserreger & erkrankte Organe |
| Ausführung: | Einzelpräparate |









































































































